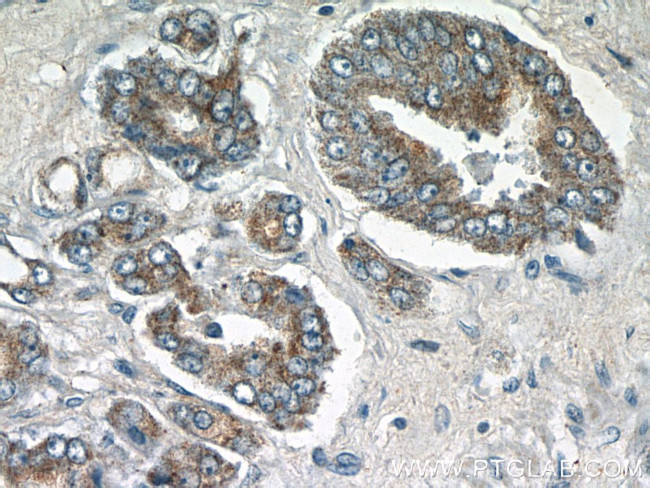
STAC2 Antibody in Immunohistochemistry (Paraffin) (IHC (P))

Search
Proteintech
STAC2 Polyclonal Antibody
{{$productOrderCtrl.translations['antibody.pdp.commerceCard.promotion.promotions']}}
{{$productOrderCtrl.translations['antibody.pdp.commerceCard.promotion.viewpromo']}}
{{$productOrderCtrl.translations['antibody.pdp.commerceCard.promotion.promocode']}}: {{promo.promoCode}} {{promo.promoTitle}} {{promo.promoDescription}}. {{$productOrderCtrl.translations['antibody.pdp.commerceCard.promotion.learnmore']}}
产品信息
24274-1-AP
种属反应
宿主/亚型
分类
类型
抗原
偶联物
形式
浓度
规格
纯化类型
保存液
内含物
保存条件
运输条件
产品详细信息
Immunogen sequence: TLRYGTSLA LMNRSSFSST SESPTRSLSE RDELTEDGEG SIRSSEEGPG DSASPVFTAP AESEGPGPEE KSPGQQLPKA TLRKDVGPMY S (65-154 aa encoded by BC109231)
靶标信息
STAC2 (SH3 and cysteine-rich domain-containing protein 2), also known as 24b2/STAC2, is a 411 amino acid protein that contains one SH3 domain and one phorbol-ester/DAG-type zinc finger. Encoding two alternatively spliced isoforms, the STAC2 gene contains over 15 thousand bases and maps to human chromosome 17q12. Human chromosome 17 comprises over 2.5% of the human genome and encodes over 1, 200 genes. Two key tumor suppressor genes are associated with chromosome 17, namely, p53 and BRCA1. Tumor suppressor p53 is necessary for maintenance of cellular genetic integrity by moderating cell fate through DNA repair versus cell death. Malfunction or loss of p53 expression is associated with malignant cell growth and Li-Fraumeni syndrome. Like p53, BRCA1 is directly involved in DNA repair, though specifically it is recognized as a genetic determinant of early onset breast cancer and predisposition to cancers of the ovary, colon, prostate gland and fallopian tubes.
仅用于科研。不用于诊断过程。未经明确授权不得转售。
篇参考文献 (0)
生物信息学
蛋白别名: 24b2/STAC2; SH3 and cysteine-rich domain-containing protein 2; SRC homology 3 and cysteine-rich domain-containing protein 2; unnamed protein product
基因别名: 24b2; 24b2/STAC2; STAC2
UniProt ID: (Human) Q6ZMT1
Entrez Gene ID: (Human) 342667